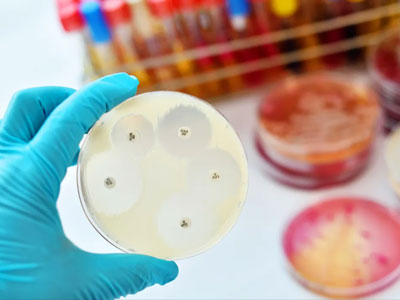
WHX Labs Dubai

This site is operated by a business or businesses owned by Informa PLC and all copyright resides with them. Informa PLC's registered office is 5 Howick Place, London SW1P 1WG. Registered in England and Wales. Number 8860726.
Tuesday, 26 January 2027: 10:00 - 18:00
Wednesday, 27 January 2027: 09:00 - 18:00
Thursday, 28 January 2027: 09:00 - 18:00
Friday, 29 January 2027: 09:00 - 17:00
Exhibition Sales
[email protected]
Sponsorship
[email protected]
Congress
[email protected]
Marketing
[email protected]
Support:
[email protected]
WhatsApp (Message only): +971 4 245 7111
Phone: +971 4 408 2888
Support hours: 9am-5pm UAE time, Monday to Friday.